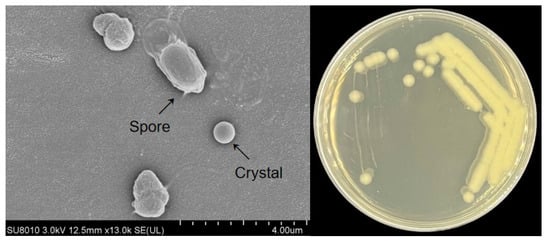

Journal Description
Insects
- Open Access— free for readers, with article processing charges (APC) paid by authors or their institutions.
- High Visibility: indexed within Scopus, SCIE (Web of Science), PubMed, PMC, PubAg, and other databases.
- Journal Rank: JCR - Q1 (Entomology) / CiteScore - Q1 (Insect Science)
- Rapid Publication: manuscripts are peer-reviewed and a first decision is provided to authors approximately 18.1 days after submission; acceptance to publication is undertaken in 2.9 days (median values for papers published in this journal in the first half of 2025).
- Recognition of Reviewers: reviewers who provide timely, thorough peer-review reports receive vouchers entitling them to a discount on the APC of their next publication in any MDPI journal, in appreciation of the work done.
- Journal Cluster of Animal Science: Animals, Arthropoda, Birds, Insects, Journal of Zoological and Botanical Gardens, Pets, Poultry, Ruminants and Veterinary Sciences.
Latest Articles
Highly Accessed Articles
Latest Books
E-Mail Alert
News
Topics
Deadline: 31 December 2025
Deadline: 31 January 2026
Deadline: 28 February 2026
Deadline: 31 March 2026
Conferences
Special Issues
Deadline: 15 December 2025
Deadline: 15 December 2025
Deadline: 22 December 2025
Deadline: 30 December 2025